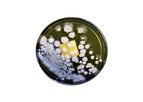
Miscellaneous Analysis

- Home
- Companies
Refine by
Industries served
- Monitoring and Testing
- Environmental
- Agriculture
- Water and Wastewater
- Soil and Groundwater
- Health and Safety
- Chemical & Pharmaceuticals
- Air and Climate
- Energy
- Manufacturing, Other
- Food and Beverage
- Construction & Construction Materials
- Waste and Recycling
- University / Academia / Research
- Medical / Health Care
- Oil, Gas & Refineries
- Plastics & Resins
- Textile
- Automobile & Ground Transport
- Aerospace & Air Transport
- Defense
- Packaging
- Government
- Metal
- Paint
- Pulp & Paper
- Mining
- Maritime/Shipbuild/Water Transport
- Electronics and Computers
- Forestry & Wood
- Banking & Finance / Insurance / Legal
- Dry Cleaning
- Domestic
- Glassware
- Retail
- Printing
- Real Estate
Environmental Industry Laboratory
230 companies found

Laboratorybased inGainesville, FLORIDA (USA)
Biological Consulting Services of North Florida, Inc. (BCS) is an established microbiological research and testing facility that incorporates a multidisciplinary team of scientists. BCS's newly renovated facilities include an on-site full scale ...
Federal and state regulatory agencies mandate the use of fecal coliforms, E. coli and/or Enterococci as microbial indicators of water quality. However, these traditional indicators of fecal pollution do not adequately assess the specific sources of ...

Laboratorybased inSioux Falls, SOUTH DAKOTA (USA)
We are very excited to be able to offer you a local option for laboratory analysis of your soil, manure and plant tissue samples. Because we know how busy you are, we offer a wide variety of options for sample submission. Samples can be sent in Pick ...
Sampling areas should represent a uniform area which could include the whole field or the reason for choosing management zones. Crop and soil properties that might influence sampling areas choices include: Historic yield differences, variable crop ...

Laboratorybased inGlen Allen, VIRGINIA (USA)
GENETWORx is dedicated to improving the lives of all people, whether it’s through COVID-19 diagnostic or antibody testing, or pharmacogenomics. GENETWORx Laboratory is a health management service company that specializes in bringing the benefits of ...

Laboratorybased inNicosia, CYPRUS
GlobeTech Group with its international operations provides a comprehensive range of services with offices and Registered Local Companies in Cyprus, Kingdom of Bahrain, Lebanon and Greece. As a 'One-Stop Shop' GlobeTech Group's aim is to offer its ...
GlobeTech provides a comprehensive range of independent technical consultancy and expert advice to its clients, ranging from advice on purchasing of cost-effective metrology and testing equipment to supply, training and support of high accuracy ...

Laboratorybased inVille Mont-Royal, QUEBEC (CANADA)
AxxonLab Inc. in Montreal Canada is an environmental testing laboratory for regulated substances. Providing Indoor Air Quality Testing, Mold Testing, Asbestos Testing, and Lead Testing services and specializes in the characterization and ...

Laboratorybased inEl Segundo, CALIFORNIA (USA)
Wallace Laboratories has many years of experience in assisting farmers, professional landscaping companies and home owners produce better gardens and improving landscape by analyzing soils, plant tissues and water. Wallace Laboratories' agronomic ...

Laboratorybased inJeffersontown, KENTUCKY (USA)
Since its establishment in 1975, Beckmar Environmental Laboratory Inc. has provided its clients with reliable and defensible sampling and analyses. Beckmar's valued clients include municipal and private utilities, state agencies, water and ...
Nuisance organism identification. Diatom identification and Bioassessment Indices. Chlorophyll Analysis. Macroinvertebrate identification and Bioassessment Indices. Sediment analysis. Stream reach characterization. Stream ...

Laboratorybased inDinslaken, GERMANY
YMC offers a wide range of innovative chromatography products, which includes UHPLC/HPLC columns (YMC-Triart), BioLC columns (e.g. YMC-SEC MAB, BioPro IEX/HIC), chiral columns (immobilised/coated CHIRAL ART), bulk media for preparative ...
YMC ProFamily reversed phase columns are based on a silica with an extremely low metal content. Low metal content suppresses polar interactions, as metal impurities cause silanol groups to become more acidic. This provides YMC ProFamily excellent ...

Laboratorybased inIstanbul, TURKEY
Operates with a principle that provides quality measurement services to customers within the broadest scope of measurement parameters, with expert staff. Responsibilities on the scope of legislations and regulations in the area of Environment, ...
'Environmental risk' is defined as possibility that directly or indirectly affects environment or human health. In order to control and prevent industrial risks, and maintain projects reaching an absolute success, we are supporting the projects ...

Laboratorybased inSan Luis Obispo, CALIFORNIA (USA)
Environmental Analytical Service (EAS) has been providing environmental air testing services since 1985. We offer a comprehensive array of analytical services that cover the needs of Indoor Air Quality and Environmental Air Quality Specialitsts. EAS ...
Semi-volatile organic compounds (SVOC) cannot be collected in a SUMMA canister because their vapor pressure is low and they attach themselves to the canister surfaces by a undefined mechanism. SVOC's in ambient and indoor air samples are collected ...

Laboratorybased inHamburg, GERMANY
IVARIO is an established company based in Hamburg, Germany, whose mission is to address questions about healthy living spaces simply and for a reasonable price. As a subsidiary of the renowned GBA lab group, we are part of one of the largest ...
The Water Test Kit PLUS is a comprehensive drinking water test, checking for no less than 32 toxic heavy metals and nitrogen compounds. The Water Test Kit Plus analyses your drinking water for 32 contaminants, including heavy metals, hardeners, ...

Laboratorybased inGurgaon, INDIA
Avigene is a young and technologically progressing organization with focus on Avian DNA testing. Avigene’s lab team has dedicated experience in the field of molecular biology specific to development of DNA based research methodologies that find ...

Laboratorybased inCape Town, SOUTH AFRICA
The Chemistry Solutions Company (Pty) Ltd trading as Waterlab on Main was established in January 2020. We are offering a qualitative, semiquantitative and affordable low-cost solution. Our water testing solutions allow us to help people protect ...
Water dissolves many minerals, chemicals, and foreign substances, then, it can get contaminated. Contaminated drinking water can carry bacteria that can harm our bodies and make us ill. Our 25 in 1 Water Test Strips are the perfect solution for a ...

Laboratorybased inCrandon, WISCONSIN (USA)
Northern Lake Service, Inc. is a fully qualified and equipped environmental analytical laboratory. Areas in which we provide service include groundwater, wastewater, drinking water, soil and sludge, and limnological surveys, among others. EPA Method ...
NLS has been involved in low-level nutrient testing since the 1970's. We performed numerous comprehensive lake management studies back then. While we no longer have the time to do whole-project lake studies, we still provide unmatched analytical ...
Laboratorybased inSan Jose, CALIFORNIA (USA)
American Lab has provided quality service since 1983. We know your calibration is the most important part of keeping your products from defects or returns which can be costly to your company. Our service is designed to fit your need to maintain a ...

Laboratorybased inVapi, INDIA
We are here to provide the best of services to the industry for the preservation and betterment of the environment. We intend to become one of the leading organisations in this field with precise techniques, prime talent, continual growth and sheer ...
Filter media, Flocculating agents (polyelectrolytes), Activated charcoal ...

Laboratorybased inDulles, VIRGINIA (USA)
Our services include a complete range of sampling and analysis of indoor environments for bioaerosols, and the identification of biological sources of IAQ problems. In addition to a full range of microbial culture analysis, our microbial services ...
Aerobiology laboratory offers a wide range of miscellaneous analyses ranging from thermophilic actinomycete cultures, Mycobacterium cultures, sulfate reducing bacteria, nitrifying bacteria, ATP testing and more. Please contact laboratory to discuss ...

Laboratorybased in, CALIFORNIA (USA)
In the world of science, Lawrence Berkeley National Laboratory (Berkeley Lab) is synonymous with “excellence.” Berkeley Lab is a member of the national laboratory system supported by the U.S. Department of Energy through its Office of Science. It is ...

Laboratorybased inSunnyvale, CALIFORNIA (USA)
Evans Analytical Group® (EAG) has been a global leader in surface analysis and materials characterization for over 31 years, delivering innovative analytical services and solutions with uncompromising scientific integrity. Since our inception in ...
EAG is an industry leader in ESD testing (Electrostatic Discharge) and Latch up testing. Our highly experienced engineering team use their industry leading knowledge and years or real world experience of the latest semiconductor technologies, ...

Laboratorybased inRaleigh, NORTH CAROLINA (USA)
First Analytical Laboratories provides inorganic analytical services for a variety of customers. While the lab got it's start serving primarily environmental engineers and stationary source testing firms, we have since expanded to work with a ...